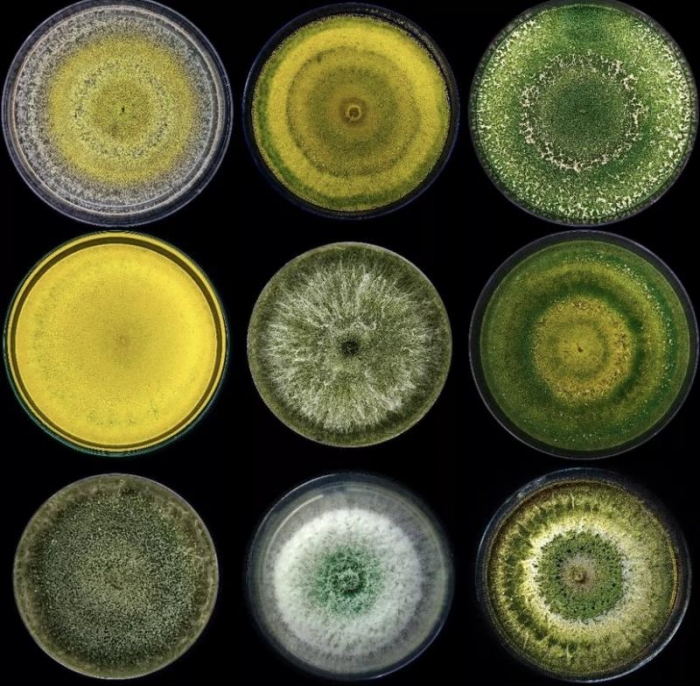
trichodermas

Sábado 18 de Enero de 2025
Leído › 2007 veces
Un estudio llevado a cabo por el grupo de investigación BIOVITIS del Instituto de Ciencias de la Vid y del Vino (ICVV), en colaboración con instituciones como la Universitat Politècnica de València, la Universidad Pública de Navarra (UPNA) y Viticultura Viva S.L., ha evaluado la eficacia de diferentes tratamientos para proteger las heridas de poda en viñedos frente a infecciones fúngicas responsables de las enfermedades de la madera de la vid (EMV). Estas enfermedades, causadas por hongos como los del género Botryosphaeria, constituyen una amenaza significativa para la salud de los viñedos.
El trabajo, realizado durante tres campañas en viñedos ubicados en la Rioja Alavesa y en el sur de Francia, analizó tratamientos físicos, químicos y biológicos. Entre ellos, se incluyeron un mástic (Bloccade®), un fungicida (Tessior®, compuesto por boscalida y piraclostrobin) y tres agentes de control biológico (ACB): Esquive® (Trichoderma atroviride I-1237), Vintec® (T. atroviride SC1) y Blindar® (T. asperellum ICC012 + T. gamsii ICC080).
En los ensayos se obtuvieron más de 1.200 aislados fúngicos en cada viñedo y campaña, asociados a cinco EMV principales: yesca, decaimiento por Botryosphaeria, excoriosis, eutipiosis y chancros causados por Cytospora. Ninguno de los tratamientos evaluados logró una protección completa contra todas las enfermedades, pero el agente biológico basado en T. atroviride I-1237 mostró resultados consistentes en la reducción de infecciones por Botryosphaeriaceae spp. durante las tres campañas en ambos viñedos.
El estudio también destacó la variabilidad en las tasas de reaislamiento de Trichoderma spp. en las plantas tratadas, que oscilaron entre el 17 % y el 100 %. Las dos cepas de T. atroviride evaluadas, presentes en Esquive® y Vintec®, registraron las tasas de reaislamiento más altas, lo que sugiere una mayor persistencia en las heridas de poda.
Los resultados, publicados en la revista Plant Disease, aportan nuevas evidencias sobre la utilidad de los tratamientos biológicos basados en Trichoderma para el manejo de las EMV, en particular para el control de hongos asociados al decaimiento por Botryosphaeria. Sin embargo, los investigadores subrayan que estos productos deben formar parte de estrategias integradas que combinen diferentes medidas para garantizar una protección más completa y sostenible en los viñedos.
Leído › 2007 veces